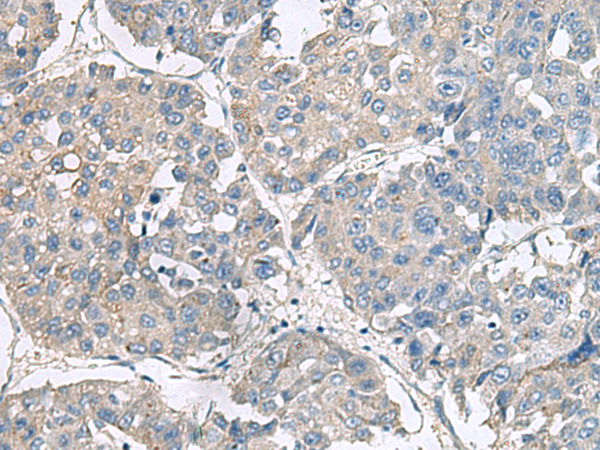
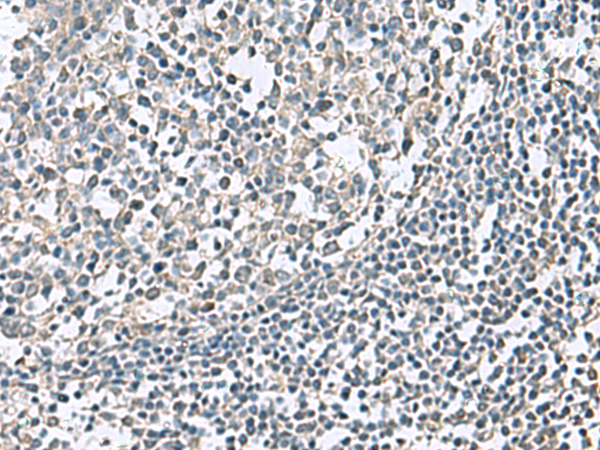
一抗

中文名稱: 兔抗NPHP1多克隆抗體
英文名稱: Anti-NPHP1 rabbit polyclonal antibody
別 名: nephrocystin 1; NPH1; JBTS4; SLSN1
相關(guān)類別: 一抗
儲(chǔ) 存: 冷凍(-20℃)
宿 主: Rabbit
抗 原: NPHP1
反應(yīng)種屬: Human
標(biāo) 記 物: Unconjugate
克隆類型: rabbit polyclonal
技術(shù)規(guī)格
|
Background: |
This gene encodes a protein with src homology domain 3 (SH3) patterns. This protein interacts with Crk-associated substrate, and it appears to function in the control of cell division, as well as in cell-cell and cell-matrix adhesion signaling, likely as part of a multifunctional complex localized in actin- and microtubule-based structures. Mutations in this gene cause familial juvenile nephronophthisis type 1, a kidney disorder involving both tubules and glomeruli. Defects in this gene are also associated with Senior-Loken syndrome type 1, also referred to as juvenile nephronophthisis with Leber amaurosis, which is characterized by kidney and eye disease, and with Joubert syndrome type 4, which is characterized by cerebellar ataxia, oculomotor apraxia, psychomotor delay and neonatal breathing abnormalities, sometimes including retinal dystrophy and renal disease. Multiple transcript variants encoding different isoforms have been found for this gene. |
|
Applications: |
ELISA, IHC |
|
Name of antibody: |
NPHP1 |
|
Immunogen: |
Fusion protein of human NPHP1 |
|
Full name: |
nephrocystin 1 |
|
Synonyms: |
NPH1; JBTS4; SLSN1 |
|
SwissProt: |
O15259 |
|
ELISA Recommended dilution: |
5000-10000 |
|
IHC positive control: |
Human liver cancerHuman tonsil |
|
IHC Recommend dilution: |
50-300 |

購(gòu)物車
購(gòu)物車 幫助
幫助
 021-54845833/15800441009
021-54845833/15800441009